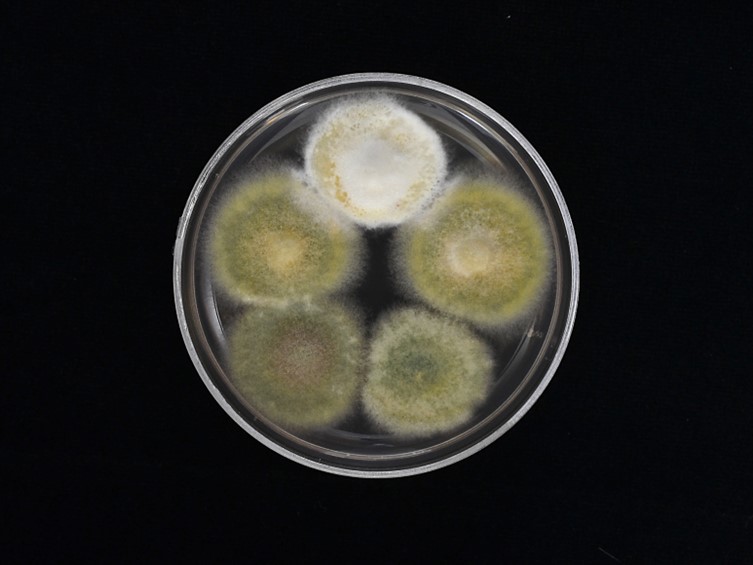

Holotype:
THAILAND, Khon Kaen Province, Phu Wiang National Park,19 Jul. 2017, K. Tasanathai, S. Mongkolsamrit, W. Noisripoom, W. Himaman, P. Jangsantear, B. Sakolrak, holotype BBH 47443, ex-type living culture BCC 85069.
Habitat:
Buried in the ground.
Host:
Coleoptera adult.
Description:
 Stromata two to three, clavate, branched, 1-1.5 cm long, 1.5-2 mm wide, becoming purple in 3 % potassium hydroxide (KOH). Rhizoids flexuous, arising from region between head and thorax of Coleoptera adults, ca 3.5 cm buried deep under the ground in the leaf litter. Upper part of the stromata fertile, orange brown, 0.5-1 cm long, 1.5-2.5 mm wide.
Stromata two to three, clavate, branched, 1-1.5 cm long, 1.5-2 mm wide, becoming purple in 3 % potassium hydroxide (KOH). Rhizoids flexuous, arising from region between head and thorax of Coleoptera adults, ca 3.5 cm buried deep under the ground in the leaf litter. Upper part of the stromata fertile, orange brown, 0.5-1 cm long, 1.5-2.5 mm wide.  Perithecia semi-immersed, oblique in arrangement with slightly protuberant ostiole, ovoid, 540-700 × 200-400 μm.
Perithecia semi-immersed, oblique in arrangement with slightly protuberant ostiole, ovoid, 540-700 × 200-400 μm.  Asci cylindrical, 8-spored, 225-320 × 3-4 μm, apical cap prominent, 3 μm wide with thin ascus tip, 1-2 μm.
Asci cylindrical, 8-spored, 225-320 × 3-4 μm, apical cap prominent, 3 μm wide with thin ascus tip, 1-2 μm.  Ascospores filiform with septa that dissociate into 16 cylindrical part-spores, hyaline, 8-12 × 1-1.5 μm. Secondary conidia produced within 24 h directly on ascospores, cylindrical with rounded apices, 3-5 × 1.5-3 μm.
Ascospores filiform with septa that dissociate into 16 cylindrical part-spores, hyaline, 8-12 × 1-1.5 μm. Secondary conidia produced within 24 h directly on ascospores, cylindrical with rounded apices, 3-5 × 1.5-3 μm.
Culture characteristics:
Colonies on PDA attaining a diam of 20 mm in 14 d, pale green to white mycelium, abundant aerial mycelium, floccose, reverse uncoloured, sporulation starts 14 d after inoculation. Phialides produced singly along the hyphae, not in whorls, paecilomyces-like, with swollen globose basal portion, 5–10 × 2–4 μm, and distinct necks, 1–4 × 1 μm. Conidia smooth-walled, hyaline, ellipsoidal to cylindrical with rounded apices, in imbricate chains, 6–10 × 3–4 μm.
Colonies on PDA attaining a diam of 20 mm in 14 d, pale green to white mycelium, abundant aerial mycelium, floccose, reverse uncoloured, sporulation starts 14 d after inoculation. Phialides produced singly along the hyphae, not in whorls, paecilomyces-like, with swollen globose basal portion, 5–10 × 2–4 μm, and distinct necks, 1–4 × 1 μm. Conidia smooth-walled, hyaline, ellipsoidal to cylindrical with rounded apices, in imbricate chains, 6–10 × 3–4 μm.
Reference:
Mongkolsamrit S, Khonsanit A, Thanakitpipattana D, et al. (2020). Revisiting Metarhizium and the description of new species from Thailand. Studies in Mycology 95: 171–251.
DOI: https://doi.org/10.1016/j.simyco.2020.04.001Species |
Strain |
Compound |
Pubchem CID |
Biological activity |
Reference |
|---|
|
Strain |
ITS | LSU | RPB1 | RPB2 | TEF1 |
|---|---|---|---|---|---|
| BCC 78206 | MT078879 | - | MN781765 | MN781812 | MN781719 |
| BCC 85068 | MN781912 | MN781864 | MN781766 | MN781813 | MN781720 |
| BCC 85069 | MN781913 | MN781865 | MN781767 | MN781814 | MN781721 |